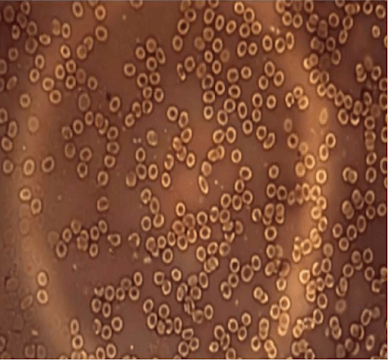

Après ce Bond dans la programmation prédictive…. Mourir peut-il réellement attendre ?

Suite au visionnage de la diffusion du dernier James Bond à la télé « mourir peut attendre » dimanche soir… Sorti en 2021.. Ah non, il est sorti en 2021, il devait sortir en 2020, mais il a pris 4 ans à réaliser depuis 2017, avec 2 réalisateurs différents, son lot d’accidents, une explosion dans le studio, la blessure de Daniel Craig l’acteur principal, un van oublié sur une base militaire qui crée la panique, de retards, 3 fins différentes, comme l’évoque cet article :
James Bond « Mourir peut attendre » : Covid, MeToo, explosion… un tournage maudit
Le 25e James Bond sort mercredi en salles. Enfin ! Car entre la pandémie et plusieurs faits divers pendant le tournage, la production de « Mourir peut attendre » a connu bien des déboires et des rebondissements.
03 oct. 2021

« Trois fins, trois complications
Pour éviter tout spoil, la production a choisi de tourner trois fins. Le 25 octobre 2019 est le dernier jour de tournage. A ce moment, seul le réalisateur et la production savent comment se termine l’histoire de James Bond époque Daniel Craig.
La date de sortie et le Covid
Mourir peut attendre devait initialement sortir en salles en octobre 2019. Après le changement de réalisateur et les péripéties de tournage, la date avait été fixée à février 2020. Mais ça, c’était avant le Covid-19. Au fil des évolutions dans le monde, le calendrier affiche novembre 2020, avril 2021, puis enfin le 6 octobre 2021. »
Je ne peux m’empêcher de voir dans ce dernier James Bond aussi clairement que le nez au milieu de la figure, la similitude effarante entre l’arme bactériologique appelée Héraclès (Hercules) récupérée par les méchants du film et les injections coco au niveau planétaire depuis plus de 3 ans…
Est-ce que l’arme nommée Héraclès dans James Bond « No time to die » (Mourir peut attendre) est réalisable ?
Synopsis : « Dans MOURIR PEUT ATTENDRE, Bond a quitté les services secrets et coule des jours heureux en Jamaïque. Mais sa tranquillité est de courte durée car son vieil ami Felix Leiter de la CIA débarque pour solliciter son aide : il s’agit de sauver un scientifique qui vient d’être kidnappé. Mais la mission se révèle bien plus dangereuse que prévu et Bond se retrouve aux trousses d’un mystérieux ennemi détenant de redoutables armes technologiques… »
« Un laboratoire biologique ultra-sécurisé du MI6 situé en plein Londres est pris d’assaut par un commando de SPECTRE commandé par Primo. Ils abattent tous les scientifiques présents dans le laboratoire, sauf un dénommé Valdo Obruchev, dont ils simulent l’enlèvement, mais il est en fait de mèche avec eux. Ils repartent en ayant dérobé une nouvelle arme biologique conçue par Obruchev, ayant pour nom de code « Projet Héraclès ». Cette arme est à base de nanorobots infectant les gens comme un virus, par simple contact tactile, et codés sur l’ADN spécifique d’un individu, les rendant mortels pour leur cible, mais inoffensifs pour les autres. »
Cette arme donc, ce sont des nanobots qui pénètrent sous la peau et peuvent cibler et buter tous les membres d’une même famille avec le même ADN ou un ADN ciblé par exemple, par simple contact… Tiens, ça nous rappelle le « vax shedding » : Le phénomène appelé « vax shedding » (contagiosité de vacciné à non vacciné) sem𝚋le toucher beaucoup de personnes à travers le monde. On en parle peu, pourtant le sujet inquiète, légitimement !
Héraclès est donc fait pour la « dépopulation » mondiale… En pleine campagne de vaccination Coco par extorsion de consentement ou pression sociale et totalitaire, à grands renforts de mensonges énormissimes et de propagande absolument dégueulasse et grossière en Pharmacronie corrompue, ils nous ont pondu ce film… Ce n’est pas de la programmation prédictive, c’est de la divulgation même pas subtile au 1er degré… C’est la révélation de la méthode !! 😤😤😤
La bande-annonce : https://youtu.be/4tMUxY9h1b4?si=tyOTBKcol_vUxbuJ

M et Q décrivent les mécanismes de contamination par la différenciation génétique dans le film « mourir peut attendre » (voir l’extrait vidéo sur cette page), et c’est là où le principe de « l’ARN messager » dans les vaccins intervient, même s’il n’est pas censé réellement exister ni avoir fait ses preuves.
La Chine est aujourd’hui largement dominée par l’ethnie Han, c’est le fruit d’une histoire qui a vu se succéder d’illustres dynasties à sa tête, comme celle des Qing… Si l’ethnie Han était directement visée, à hauteur de plusieurs millions d’individus, on peut comprendre la panique et les mesures totalitaires des Chinois, vu sous l’angle Héraclès… Sinon, rien ne justifiait un tel délire totalitaire en confinant des millions à Shanghai basé sur un seul test PCR positif frauduleux, sauf bien sur pour tester les limites de la soumission de masse, torturer des millions d’habitants, et faire peur au reste ! Ce qui a été, il faut bien le reconnaitre la tactique perverse appliquée en boucle depuis plus de 3 ans à tous les publics bien obéissants et collabos du narratif !


DES E-MAILS DÉTERRÉS DE 2020 PROUVENT QUE LE TEST PCR COVID EST UNE ARNAQUE
L’OMS confirme que le test PCR Covid-19 est défectueux : les estimations de « cas positifs » n’ont aucun sens. Le confinement et le « vaccin » n’ont aucune base scientifique

Le gouvernement Chinois est allé jusqu’à éliminer, ou en tous cas faire comme s’il l’avait fait, des lanceurs d’alerte qui voulaient divulguer les premiers signes d’épidémie en Chine, concernant le Coronacircus, et les faire mourir du Grovide lui-même…
Exemple de leurs fake news inversées :
Un docteur Chinois qui avait annoncé l’arrivée de l’épidémie le 31 décembre sur Wechat est entre la vie et la mort. Il avait été menacé par les autorités chinoises lors de ses divulgations.
9 février 2020

C’est l’un des premiers médecins à avoir alerté sur la dangerosité du coronavirus mais on l’a réduit au silence. Li Wenliang, 34 ans, est en train de devenir un héros en Chine, après sa mort le 7 février, des suites du virus.
Ophtalmologue à Wuhan, il tire la sonnette d’alarme dès la fin du mois de décembre. Sanctionné avec des collègues, il devient un symbole du manque de transparence des autorités chinoises. Quelques jours avant son décès, il a raconté avoir été forcé de signer une lettre reconnaissant qu’il avait fait “des commentaires erronés” et qu’il avait “fortement perturbé l’ordre social”.

Li Wenliang est mort avant la naissance de son deuxième enfant.

#ALERTE ⚠️ DES VÉRITÉS QUI DÉRANGENT, QUI ? ⚠️
Dans le monde entier, depuis le début de l’épidémie, plusieurs journalistes indépendants, dissidents politiques et lanceurs d’alerte ont été interpellés ou ont disparus !
❗️On se souvient de Li Wenliang, ce jeune médecin de Wuhan, mort du Covid-19, l’un des premiers lanceurs d’alerte de la pandémie. Ce que l’on sait moins, c’est qu’il a lui-même été alerté par le docteur Aï Fen, cheffe des urgences à l’hôpital central de Wuhan, réduite au silence par le régime Pékin … aujourd’hui disparue !
⁉️ Qui sont ces lanceurs d’alerte menacés pour avoir dit la vérité sur la pandémie :
Le docteur Aï Fen, lanceuse d’alerte de la pandémie, a disparue ! ON: 10 AVRIL 2020
Li Wenliang est mort du « virus » ? il validait l’existence du coco ? L’arme létale est en fait dans les injections pas dans la fausse plandémie fantôme.
Toute cette histoire scénarisée du false flag de Wuhan et du marché aux animaux, puis ensuite des fuites bactériologiques du laboratoire P4 sur place par accident ou volontairement n’était un énorme enfumage….
Non seulement leur Grovide n’était pas dangereux mais en plus il n’existait pas en tant que tel, puisqu’il n’a absolument jamais été purifié et isolé nulle part !
Ils ont escamoté les statistiques de la grippe saisonnière et collé l’étiquette de décès par Grovide 19 à tous les décès confondus… Cette énorme mascarade fait partie de leur tactique d’inversion encore :
Ils font croire qu’ils nous camouflent une énorme menace sanitaire en Chine et tuent les lanceurs d’alerte, pour après nous vendre une pseudo pandémie qui n’a jamais eu lieu !!
Le but était de confiner le monde entier et d’injecter leurs poisons et nanobots un maximum de gens, toutes populations confondues. Le danger de type Projet Héraclès vient des picouses, pas du coco fantôme. Le projet Héraclès c’est bien ce qu’il y a comme nanotechnologies dans les vaccins, pas un pseudo « virus » issu d’un Pangolin ou d’une chauve-souris au marché de Wuhan !
TOUS LES TOUBIBS -QUI PRETENDENT QU’UN VIRUS EST SORTI DE WUHAN- SONT DES ESCROCS! « La seule chose qui est sortie du laboratoire de Wuhan, c’est la peur. C’est la seule chose qui se transmet. Et juste après, arrive le test. C’est le test, un test-bidon, qui est le socle sur lequel s’appuie tout ce qu’on a vécu pendant deux ans. »



Par contre, ce type de projet de « génocide ethnique » par l’utilisation d’armes bactériologiques a déjà été mis au point dans l’histoire, en Afrique du Sud, dans le silence le plus complet…
Le Projet Coast était un programme d’armes bactériologiques et chimiques secret-défense du gouvernement d’Afrique du Sud durant l’apartheid, bénéficiant du silence des grandes puissances occidentales. Ce programme, actif de 1981 à 1993, visait à contrôler la démographie de la population noire d’Afrique du Sud en créant des armes biologiques ne s’attaquant qu’aux populations noires.
En 1981, Wouter Basson (surnommé par la suite « Docteur La Mort »), médecin personnel du président Pieter Botha, fut nommé, avec le grade de lieutenant-colonel, chef du « Projet Coast » chargé de développer des armes bactériologiques et chimiques et que l’état-major de l’armée sud-africaine présenta comme un « programme défensif » lancé secrètement par le général Constand Viljoen, alors chef des forces de défense d’Afrique du Sud (South African Defence Force) puis plus tard fondateur du Front de la liberté.
Dans le documentaire Marchands d’anthrax : vers une guerre bactériologique ?, Wouter Basson affirme à Roberto Coen que « la Bombe noire, visant à infecter uniquement la population noire, a été un projet génial, le plus amusant de sa vie. ».
En 1983, une bactérie capable de tuer seulement les noirs aurait été déclarée opérationnelle : le poison ne serait pas basé sur la couleur de peau mais sur la différence de polymorphisme et fonctionnerait donc sur un albinos d’origine africaine mais pas sur un Indien à peau noire. Une arme capable de stériliser seulement les femmes d’origine africaine aurait aussi été créée durant le Projet Coast, fonctionnant aussi sur la différence polymorphique, l’arme fonctionnait comme un vaccin immunisant le corps contre le sperme. Si le projet a développé de nombreux poisons (anthrax dans des cigarettes ou des enveloppes, cyanure de potassium dans des cigares ou chocolats, du botulinum dans le lait, des tournevis et des parapluies empoisonnés ou du paraboxon dans le whisky, de nombreux aliments au thallium) contaminant des produits destinés à être en contact avec les Noirs, l’existence ou l’opérationnabilité de cette bactérie ou de ce vaccin n’est pas attestée.
Le 22 avril 2002, au bout de trente mois de procès, 46 chefs d’accusation, 153 témoins à charge et plus de 40 000 documents relatant diverses méthodes d’empoisonnements et d’assassinats, le cardiologue sud-africain Wouter Basson est acquitté par le juge Hartzenberg qui lui accorde l’amnistie. L’État sud-africain fait appel devant la Cour suprême qui refuse un nouveau procès.
En septembre 2005, la cour constitutionnelle juge que le docteur Basson peut être rejugé pour crimes contre l’humanité. Aucune procédure judiciaire en ce sens n’a cependant été engagée dans ce but. (Source : https://fr.wikipedia.org/wiki/Projet_Coast)

L’analyse de ce projet, qui a été mis en œuvre, et dont beaucoup de nos concitoyens n’ont même pas connaissance, autorise plusieurs réflexions, dont celles-ci en conclusion dans l’article :
Personne n’a été condamné. Malgré la réalité avérée du projet, son concepteur a été acquitté lors d’un procès, amnistié, et – pire encore – est encore médecin, il vit aujourd’hui une vie normale et coule des jours heureux. Un peu comme Fabius qui a continué une superbe carrière jusqu’à la présidence du Conseil constitutionnel… Bref, l’hyperclasse mondiale semble persuadée de s’en sortir au vu de ce précédent.
ET SURTOUT : LA DISQUALIFICATION POUR « COMPLOTISME » N’EST QU’UNE FACILITÉ POUR LES GOUVERNEMENTS MODERNES LEUR PERMETTANT D’UTILISER LE NIVEAU D’INCULTURE ET DE SOUS INFORMATION DES POPULATIONS ET DES OPINIONS PUBLIQUES CONTRE ELLES MÊMES AFIN DE FAIRE TAIRE, DE CACHER OU DE FAIRE REFOULER CERTAINES INTUITIONS SAINES.
Sitographie de sources médiatiques mainstream, plurielles et officielles pour comprendre la véracité et la réalité de ces faits abjects, qui peuvent être difficiles à croire :
Article de presse de Libération datant de 2012 : https://www.liberation.fr/planete/2012/05/27/afrique-du-sud-le-fantome-du-docteur-folamort_821760/
Reportage Arte : https://www.youtube.com/watch?v=Hme1xB5OfTY&t=12sance
France 3 : https://www.youtube.com/watch?v=RKGDCnWTWIo
La Croix : https://www.la-croix.com/Monde/En-Afrique-Sud-retour-Docteur-Mort-2021-02-02-1201138433
Autre lien universitaire : https://esmaparis1.com/2018/04/27/docteur-la-mort-et-le-projet-coast/
Lien connexes pour approfondir :
Coast ne sera pas le premier, on a connu des expérimentations du même genre en France par la CIA dans des villages pendant la guerre froide : Pont-Saint-Esprit, 1951 : https://fr.wikipedia.org/wiki/Affaire_du_pain_maudit, https://www.slate.fr/lien/52301/cia-lsd-drogues-san-francisco-orgasme-de-minuit , Opération Sea Spray en 1950 où la CIA a relâché une bactérie dans la baie de San Francisco (11 hospitalisations) : https://www.smithsonianmag.com/smart-news/1950-us-released-bioweapon-san-francisco-180955819/
Voir aussi le Projet 112 : test de vaporisation d’un bacille dans les ampoules du métro de New York entre le 7 et le 10 juin 1966, déclenchant une épidémie : https://fr.m.wikipedia.org/wiki/Projet_112.
Voir aussi : « Un village empoisonné par la CIA : Pont Saint-Esprit 1951 » (Olivier Pighetti), diffusé sur France 3 (collection « docs interdits », 28 juillet 2015) : https://www.dailymotion.com/video/x5xgsnr et aussi : https://iatranshumanisme.com/2015/07/11/france-3-un-village-empoisonne-par-la-cia-pont-saint-esprit-1951/
Alors le prochain test de génocide planétaire grandeur nature est prévu pour quand ? L’écriture du scénario et sa répétition générale s’est déjà produite… Vous pensez être revenus à la « normale » ? Leur nouvelle normalité n’est faite que de prochaines fausses pandémies, de vrais empoisonnements par les vaccins et tout le reste, et de guerres permanentes aux 4 coins de cette dimension pour nous emmener de force vers leur prison numérique totale, en passant par la case de l’abattoir…

NOUVELLE PANDÉMIE EN VUE !
Je ne vous ai rien dit bien évidemment.. Il faut que cela reste réel UNE FOIS DE PLUS !
Regardez bien les dates dans le document. J’avais déjà, il y a 2 ans, alerté sur cette 2nd fausse pandémie et elle approche, préparation en 2024 !
Ils nous prennent pour des cons, mais le pire, c’est que ça va encore fonctionner car nombreux vont obéir, tout en ayant conscience de s’être fait avoir une première fois !
N’oublions pas qu’au bout de l’obéissance, il y a la dictature et les plans sont prêts !
En octobre 2017 le Johns Hopkins center for health security écrivait un scénario futuriste sur une pandémie de SPARS 2025-2028
Ils prévoyaient un vaccin, le Corovax, des lanceurs d’alerte sur les effets indésirables, la reconnaissance des victimes notamment de celles souffrant de graves troubles neurologiques…
Bizarre non ?
Fin 2022 Bill GATES a prédit une nouvelle contagion catastrophique pour l’année 2025 plus terrible que la précédente – Marquez la date et soyez prêt !
L’HISTOIRE EN UN COUP D’ŒIL
< Au fil du temps, il est devenu évident que la cabale mondialiste qui cherche à mettre en place un gouvernement mondial unique nous annonce régulièrement ce qu’elle s’apprête à faire. Les simulations de pandémie sur table, par exemple, sont une forme de répétition générale.
< En 2017, le Johns Hopkins Center of Health Security a organisé une simulation de pandémie à coronavirus appelée scénario SPARS Pandemic 2025-2028. En octobre 2019, la Fondation Bill et Melinda Gates, en collaboration avec Johns Hopkins et le Forum économique mondial, a organisé l’événement 201.
< Comme dans le scénario de pandémie SPARS, l’événement 201 impliquait une épidémie de coronavirus hautement infectieux, mais l’objectif principal (sinon unique) de l’exercice portait sur la manière de contrôler l’information et de maîtriser la « désinformation », et non sur la manière de découvrir et de partager efficacement les remèdes…
< Le 23 octobre 2022, Gates, Johns Hopkins et l’Organisation mondiale de la santé ont organisé conjointement « un exercice de défi mondial » baptisé « Contagion catastrophique », impliquant un nouvel agent pathogène appelé « syndrome respiratoire épidémique sévère à entérovirus 2025 » (SEERS-25), qui touche principalement les enfants et les adolescents.

Pourquoi les pandémies manufacturées vont se poursuivre
À ce stade, il est clair que la « biosécurité » est le moyen choisi par la cabale mondialiste pour prendre le pouvoir sur le monde. L’OMS s’efforce de s’assurer le pouvoir exclusif sur la réponse aux pandémies dans le monde par le biais de son traité international sur les pandémies qui, s’il est mis en œuvre, éradiquera la souveraineté de toutes les nations membres.
En fin de compte, l’OMS a l’intention de dicter tous les soins de santé. Le 13 décembre 2022, l’OMS a annoncé que Sir Jeremy Farrar, directeur du Wellcome Trust – qui s’est associé au Dr Anthony Fauci pour étouffer l’affaire de la fuite du laboratoire C0VID – avait été choisi comme nouveau responsable scientifique11.
Le traité de l’OMS sur les pandémies est la porte d’entrée d’un régime totalitaire mondial et descendant, un gouvernement mondial unique. Mais pour s’assurer ce pouvoir, ils auront besoin de plus de pandémies. C0VID-19 n’a pas suffi à lui seul à rallier tout le monde à une unité centralisée de réponse à la pandémie, et ils le savaient probablement dès le départ.
Ainsi, la raison pour laquelle nous pouvons être sûrs qu’il y aura d’autres pandémies, qu’elles soient fabriquées en utilisant uniquement la peur et le battage médiatique ou une véritable arme biologique créée dans ce but précis, est que le plan de prise de contrôle, alias The Great Reset, est basé sur le principe que nous avons besoin d’une surveillance mondiale de la biosécurité et d’une réponse centralisée.
La biosécurité, à son tour, est la justification d’un passeport vaccinal international, que le G20 vient de signer, et ce passeport sera également votre identification numérique. Cette identification numérique sera alors liée à votre score de crédit social, au suivi de votre empreinte carbone personnelle, à vos dossiers médicaux, à vos dossiers scolaires, à vos dossiers professionnels, à votre présence sur les médias sociaux, à vos dossiers d’achat, à vos comptes bancaires et à une monnaie numérique programmable de la banque centrale (CBDC).
Une fois toutes ces pièces entièrement connectées, vous serez dans une prison numérique et la cabale au pouvoir – qu’elle soit officiellement un gouvernement mondial à ce moment-là ou non – aura un contrôle total sur votre vie, du berceau à la tombe.

L’OMS prévoit-elle de déclencher des confinements climatiques comme prochaine « pandémie »?
Maintenant que l’arnaque du coronavirus de Wuhan (Covid-19) est terminée, l’Organisation mondiale de la santé (OMS) est occupée à préparer son prochain plan tyrannique sous la forme d’une nouvelle série de confinements, cette fois pour arrêter le « changement climatique », en plus bien sûr de leurs réjouissances du plan Spars 2025.



Symbolismes d’Héraclès / Hercule.. le nom de l’arme biologique et nanotechnologique du film :

Quelle est le symbole d’Hercule ?
Le nœud d’Heraklès semble faire allusion à celui que le héros utilisait pour attacher les pattes de la peau de lion qu’il portait sur lui. Cette peau était en effet, celle du lion de Némée terrassé par Hercule ; elle était indestructible, ce qui constituait une belle armure !
Comment le mythe d’Héraclès Illustre-t-il l’unité du monde grec ?
Héraclès, que les Romains nomment Hercule, fut le seul héros honoré dans l’ensemble du monde grec et le seul humain à se voir accorder l’immortalité parmi les dieux. Il est le protecteur des athlètes et le dieu qui écarte les dangers.

Quelle est la morale des 12 travaux d’Hercule ?

Lyutsifer Safin, le méchant de James Bond qui détient l’arme d’Héraclès, s’est pris pour Dieu… avant de mourir !
Même le personnage du méchant se prénomme pratiquement « Lucifer »…

À travers eux, Hercule accomplit un fabuleux destin qui va lui permettre de gagner l’immortalité et de devenir un dieu de l’Olympe. Hercule se réalise. Ainsi, le mythe nous donne à comprendre le travail, non pas comme un châtiment, non pas comme un exploit sportif, non pas comme une souffrance, mais comme une épreuve.

Le WEF (Forum Economique Mondial de Klaus Schwab) nous impose ses normes de développement durable de façon totalitaire et insidieuse avec leur Agenda 2030, anciennement Agenda 21, en nous faisant croire que c’est pour sauver la planète, dont ils se foutent éperdument et détruisent à tout va en l’empoisonnant, l’asservissant et l’appauvrissant !
Leur « méritocratie » ou 12 travaux d’Hercule transposés aux 17 résolutions de leur Agenda 2030…

Traduction des 17 objectifs du développement durable de l’Agenda 2030 WEF https://odysee.com/@Septia:6/Traduction-des-17-points-de-l’Agenda-2030:d

Ma version personnelle des grandes lignes du programme de Klaus Schwab en vidéo… https://www.youtube.com/watch?v=Xnx1Yy2Stu4&t=36s

Résumé en quelques mots de ce que signifiera la fusion de votre être biologique avec votre identité numérique dont parlent Klaus Schwab et sa clique de psychopathes :



Votre degré de déni cognitif et d’obéissance déterminera notre niveau général d’asservissement à ce programme totalitaire sous couvert de sauvetage nécessaire de la planète, dans l’enfumage général le plus complet !

Dans mon premier long métrage « CoronaXFiles : Recyclage ou Libération !? » sorti en mars 2022 sur la plandémie eugéniste C19 bien planifiée longtemps à l’avance, à coup de simulations grandeur nature, de prévisions démographiques et de répétitions d’autres enfumages précédents comme le H1N1, etc… j’avais exposé ce court passage des recherches de Mike Adams, sur l’arme ultime du graphene et des nanobots délivrés dans les injections et connectées, déclenchables à distance via les tours 5G et les téléphones cellulaires.. à 1H40 dans le film, juste après avoir évoqué l’interface des nanorouters et nanocircuits qui permettent de contrôler les injectés via les ondes.






Notre réalité devient un James Bond :
5G REMOTE KILL VECTOR (le Vecteur 5G d’assassinat à distance) : Un article scientifique révèle que les signaux des téléphones portables peuvent activer la libération de charges utiles biologiques à partir de l’oxyde de graphène injecté dans le corps
Le signal est dû aux micronanoparticules, Nano-bots, Nano-techs, contenus dans le produit génique nucléaire, le Graphene permet la connexion avec la 5 G. La fonction du Bluetooth sur Androïd permet de capter le signal émis.
☢ La 5G pourrait être un « Kill Switch » (interrupteur de la mort) pour libérer des substances mortelles dans les vaccins et test PCR. ☣
En outre le graphène transforme les injectés en émetteur 5G selon cet article de Mike Adams, scientifique environnemental Américain.
Bien sûr, le dernier James Bond, même s’il surprend par son timing… n’est pas le premier film ni première série télé à prédire des campagnes d’eugénisme ou d’hybridation…..
Je l’avais même remarqué dans la série X-Files, cet eugénisme prédictif, saison 11, en 2017-2018 :
Prédictions X-Files pour le génocide ou/et l’hybridation/mutation CoronaX-Files ! https://odysee.com/@MarcGray2021:c/Pr%C3%A9diction-XFiles-et-CoronaXFiles-sml:6

Légère programmation prédictive, Chris Carter, le réalisateur de la série, non ? De qui as-tu reçu le scénario au juste ? Ah oui j’oubliais encore, c’est la CIA Bavaroise derrière Bloodywood… On les remercie de nous pourrir la vie et aussi la mort, et de nous l’annoncer par avance dans les séries de pseudo-fiction !!!
Hécatombe vaccinale pour une extinction de l’espèce humaine ou campagne d’hybridation générale pour faire muter une certaine population, ou les 2 ?
Évidemment, de nombreux films dystopiques et d’horreur ainsi que des séries TV ont mis en scène une contagion par un virus ou une bactérie… la plupart tuant ou transformant leurs victimes en zombies assoiffés de sang et de cerveaux…
La série TV Stargate SG-1, en 2001, nous proposait un scénario aussi étrange qu’X-Files dans l’un de ses épisodes intitulé « 2010 » !
Dans cet épisode de Stargate, ils vaccinent tout le monde pour stériliser la planète.
Titre original : 2010 (épisode 4×16)

Dix ans dans le futur, les anciens membres de Sg-1 doivent parvenir à envoyer un message dans le passé pour empêcher l’annihilation de la race humaine.
https://www.stargate-fusion.com/series/1-stargate-sg-1/4-saison-4/81-2010.html


En 2010, les Goa’ulds ont été vaincus grâce aux Aschens, qui ont partagé leur technologie avec la Terre, qui est par ailleurs entrée dans la Confédération Aschen.
Dix ans ont passé. Les Aschen, une race extraterrestre très avancée, a finalement réussi à vaincre les Goa-uld. Mais l’équipe du SG-1, aujourd’hui dissoute, découvre l’existence d’un terrible complot…
Aujourd’hui, les Aschen sont très respectés sur Terre, une alliance lie désormais les deux civilisations. A l’époque, seul Jack O’Neill s’était déclaré contre ce traité. Il n’est pas venu à la cérémonie. Samantha Carter a, quant à elle, épousé Joe, un ambassadeur avec qui elle tente vainement d’avoir un enfant. Le Dr. Fraser suggère à Samantha de faire des examens. Quelques jours plus tard, Samantha Carter apprend qu’elle ne pourra pas avoir d’enfants, contrairement à ce que prétendent les médecins Aschen qui l’ont examinée. Elle consulte l’ordinateur central des Aschen et découvre que le taux de natalité des humains a chuté de près de 90% en deux ans seulement, depuis que les Aschen ont proposé un vaccin doublant l’espérance de vie humaine. D’après Carter, l’utilisation de ce vaccin serait un moyen efficace de stériliser toute la population. Teal’c estime que d’ici un siècle, seule une poignée d’humains subsistera, les Aschen disposeront de la planète pour eux tous seuls. Samantha pense qu’il est temps d’agir et propose de tenter un voyage dans le temps : revenir en arrière pour corriger le passé.
Les anciens membres de SG-1 décident donc d’envoyer un message dans le passé (en activant la porte pendant une éruption solaire) afin que le SGC ne contacte jamais la planète d’origine des Aschens.
A l’écran et dans la vie réelle…. les mêmes intentions mais pas les mêmes aboutissants !
Les rapports d’une hécatombe vaccinale bactériologique et nanotechnologique planétaire dans la vraie vie, au contraire des projets eugénistes des méchants dans James Bond ou dans la série X-Files qui sont toujours défaits à l’écran et n’arrivent pas à leurs fins, sont disponibles absolument partout hors merdias de masse… et j’ai déjà fait ma part du travail pour les partager, sans beaucoup d’intérêt évidemment dans cet Hôpital Psychiatrique géant peuplé de neuneus sadomasos décérébrés et collabos du narratif totalitaire entropique à tout prix et amplement majoritaires en nombre… En voici un exemple :

‼️ »1000 articles évalués par des pairs sur les blessures liées au « vaccin » – Dr Mark Trozzi – 28 septembre 2023
⚠️ Voici une bibliothèque organisée de plus d’un millier d’articles évalués par des pairs qui montrent que les «vaccins» contre le Covid-19 sont nocifs.
Une bibliothèque ultime et organisée pour renforcer la recherche, étayer les poursuites judiciaires, soutenir les accusations criminelles ou effectuer un changement politique.
C’est également une preuve abondante pour quiconque continue d’adhérer à l’allégation « sûr et efficace », mais est prêt à examiner les preuves.

https://drtrozzi.org/fr/2023/09/28/1000-peer-reviewed-articles-on-vaccine-injuries/
Il existerait des méthodes pour combattre, contourner ou désactiver le « vax-shedding », la contamination de ces nanobots des vaccinés aux non vaccinés.
Des scientifiques de haut niveau prouvent que les nanorobots de graphène contenus dans les vaccins COVID passent des personnes vaccinées aux personnes non vaccinées, mais qu’il existerait un moyen de les éliminer.
Le 5 décembre 2023
L’énigme des nanobots en graphène :
Cachée dans les profondeurs des vaccins COVID-19, une énigme attend d’être découverte : les nanobots de graphène. Ces entités microscopiques, composées d’oxyde de graphène, possèdent un sombre programme qui menace la santé et l’autonomie humaines.
Mais comment le graphène se retrouve-t-il dans les vaccins COVID-19 ?
C’est par le biais d’un processus de fabrication secret, entouré de plusieurs couches de tromperie.
La confirmation se trouve dans un document soumis à la FDA par Pfizer, pour obtenir l’autorisation d’utilisation d’urgence (EUA). Un document que la FDA ne voulait pas divulguer pendant au moins 75 ans, mais qu’elle a été contrainte de rendre public par un juge fédéral.
Ce document confirme qu’il est parfaitement possible que de l’oxyde de graphène toxique se retrouve dans les vaccins Covid-19, en raison du processus de fabrication !
Début janvier 2022, le juge fédéral Mark Pittman a ordonné à la FDA de publier 55.000 pages par mois de documents soumis par Pfizer, et depuis lors, le PHMPT a publié tous les documents sur son site web au fur et à mesure de leur publication.
Malheureusement, l’un des documents les plus récents publiés par la FDA, enregistré sous le numéro 125742_S1_M4_4.2.1 vr vtr 10741.pdf, confirme l’utilisation d’oxyde de graphène dans le processus de fabrication du vaccin Covid-19 de Pfizer. Il prouve que les régulateurs de la médecine, les médias grand public, les vérificateurs de faits et Pfizer vous ont tous menti.
Pfizer indique à la page 7 de l’étude, à la section 3.4, ce qui suit : – Le vaccin est fabriqué à partir de l’oxyde de graphène – Source : Page 7
Le graphène, avec ses propriétés exceptionnelles et son incroyable résistance, a captivé la communauté scientifique. Mais lorsque ce formidable matériau est exploité pour créer des nanorobots, un sinistre courant sous-jacent apparaît. Ces machines à l’échelle nanométrique, mues par la puissance du graphène, ont le potentiel de s’infiltrer dans notre corps sans être détectées, devenant ainsi une armée silencieuse de destructeurs.
Une fois à l’intérieur, les nanorobots de graphène peuvent déclencher une cascade de dévastations. Ils ont la capacité d’interagir avec nos cellules, nos tissus et même notre patrimoine génétique, devenant ainsi des intrus malveillants à l’intérieur de notre corps. Ces minuscules entitée peuvent faire des ravages dans nos systèmes biologiques, causant des dégâts sans précédent et des dommages irréparables.
L’un des aspects les plus horribles des nanorobots en graphène est leur capacité à manipuler et à contrôler nos fonctions corporelles. Imaginez un scénario dans lequel ces agents insidieux prendraient le pas sur nos systèmes naturels, dictant nos pensées, nos émotions et nos actions physiques. Notre autonomie serait réduite à néant et nous deviendrions de simples marionnettes entre les mains de ces forces malveillantes. La perspective d’un monde dystopique où chacun de nos mouvements est orchestré par ces destructeurs silencieux fait froid dans le dos.
Des découvertes alarmantes :
Philippe van Welbergen, expert renommé en nanotechnologies, a fait des progrès décisifs pour découvrir la vérité sur les nanoparticules de graphène et leur présence potentielle dans les vaccins COVID-19.
Grâce à une analyse méticuleuse d’échantillons de vaccins, le Dr van Welbergen a décelé des indices inquiétants de la présence de graphène, ce qui soulève des inquiétudes quant à son impact sur la santé humaine.
Ses conclusions établissent une corrélation entre la présence de graphène et l’apparition de troubles de la coagulation sanguine qui laissent perplexe et la destruction de globules rouges essentiels. Ces révélations exigent une attention urgente et une enquête plus approfondie sur la sécurité et les conséquences à long terme des injections contenant du graphène.
Vous trouverez ci-dessous une image de globules rouges sains typiques, vus au microscope, ce à quoi le sang devrait ressembler. Il n’y a pas de coagulation ni de corps étrangers.
Étranges caillots sanguins et troubles vasculaires : L’une des découvertes alarmantes concernant les nanorobots de graphène est leur association avec la formation de caillots sanguins inhabituels et de troubles vasculaires.
Des études scientifiques ont révélé que ces minuscules agents, lorsqu’ils sont introduits dans la circulation sanguine, ont la capacité de déclencher des mécanismes de coagulation anormaux, entraînant des complications potentiellement mortelles.
L’interaction entre le graphène et les composants sanguins peut perturber les processus de coagulation normaux, mettant en péril la santé cardiovasculaire et augmentant le risque d’accidents vasculaires cérébraux, de crises cardiaques et d’autres troubles vasculaires.
L’image suivante montre une personne à qui l’on a injecté le vaccin expérimental Covid.
Le sang est coagulé et les globules rouges difformes sont agglutinés. La cellule encerclée dans l’image est un globule rouge sain, l’un des rares de l’image, placé à côté des fibres de graphène.
Vous pouvez voir la taille des fibres de graphène par rapport à la taille d’un globule rouge. Les fibres de cette taille bloquent les capillaires. Vous pouvez également voir que les fibres de graphène sont creuses et contiennent des globules rouges.

Ces transporteurs vitaux d’oxygène sont essentiels au maintien de la santé et du bien-être. Cependant, lorsqu’ils sont exposés à des nanorobots de graphène, les globules rouges peuvent subir des dommages importants, ce qui nuit à leur capacité à transporter efficacement l’oxygène.
Cette perturbation peut avoir des conséquences considérables, allant d’une baisse d’énergie et d’une altération des fonctions cognitives à une détérioration de la santé des organes et à une diminution de la vitalité générale.
Transmission des vaccinés aux non-vaccinés : Des études récentes ont également soulevé des inquiétudes quant à la transmission potentielle des nanorobots de graphène des personnes vaccinées à la population non vaccinée.
Alors que l’objectif premier de la vaccination est de conférer une protection contre des maladies spécifiques, des rapports troublants suggèrent que les nanobots de graphène, utilisés dans certains processus de fabrication des vaccins, pourraient être transmis par inadvertance à des personnes qui n’ont pas reçu le vaccin.
Cela soulève de profondes questions éthiques sur la diffusion de nanomatériaux non testés et potentiellement nocifs au sein de la population.
L’image ci-dessous représente un échantillon de sang d’un enfant de trois ans non vacciné. Elle montre des morceaux ou « éclats » de graphène qui « sont le résultat d’une dissémination », c’est-à-dire que le graphène a été transmis par des parents « vaccinés » à leur enfant non vacciné.

L’image suivante est celle d’un échantillon de sang d’un enfant non vacciné de huit ans dont le sang a été contaminé et détruit par la transmission de graphène provenant des personnes de son entourage qui ont reçu une injection de Covid. Le bras droit et la partie supérieure de la jambe droite de l’enfant sont pratiquement paralysés, l’enfant est incapable de lever son bras droit et sa cuisse ne fonctionne plus correctement.

Le phénomène troublant de la transmission du graphène
Au fur et à mesure que l’enquête progresse, une révélation encore plus effrayante apparaît. Des preuves suggèrent la transmission potentielle de nanoparticules de graphène de personnes vaccinées à des personnes non vaccinées, ce qui soulève des questions alarmantes sur les conséquences involontaires des campagnes de vaccination de masse.
Ce phénomène, s’il est confirmé, a des implications importantes pour la population non vaccinée, qui ne se doute de rien. Il souligne la nécessité urgente de mener des études approfondies pour déterminer l’étendue et les conséquences de la transmission du graphène, ainsi que les risques potentiels pour les personnes vulnérables.
Dans le domaine des nanobots de graphène, un phénomène troublant est apparu : la transmission potentielle de ces agents microscopiques de personnes vaccinées à des personnes non vaccinées.
Cette révélation a de profondes répercussions sur la santé publique et soulève des inquiétudes quant aux conséquences involontaires et aux implications éthiques d’une exposition généralisée au graphène.
Un avenir dystopique dévoilé :
Les implications des nanorobots de graphène vont bien au-delà du domaine de la santé physique. Elles laissent entrevoir un avenir dystopique où l’autonomie individuelle est compromise et où le contrôle repose entre les mains de ceux qui déploient ces espions microscopiques.
Le potentiel de surveillance, de manipulation et même d’asservissement de la société se profile à l’horizon, érodant le tissu même de notre libre arbitre.
Dans un monde qui vacille au bord de l’incertitude, une réalité glaçante et dystopique émerge à mesure que l’intersection sinistre des nanorobots de graphène, de la technologie de l’ARNm et de la nanotechnologie est mise en évidence.
Échapper aux griffes des nanorobots de graphène :
Trouver un moyen d’échapper aux griffes des nanorobots de graphène devient une préoccupation majeure pour ceux qui aspirent à la liberté et à la souveraineté corporelle.
Bien que le chemin de la libération ne soit pas toujours évident, il existe des mesures à prendre pour minimiser l’exposition et aider à l’élimination de ces particules insidieuses.
Stratégies de désintoxication : Éliminer le graphène de l’organisme en toute sécurité
À une époque marquée par l’infiltration des nanomatériaux à base de graphène dans divers aspects de notre vie, les inquiétudes concernant leurs implications potentielles sur la santé se sont accrues. L’exposition involontaire au graphène et son accumulation potentielle dans l’organisme ont soulevé des questions sur la manière d’éliminer efficacement ce matériau puissant.
Amélioration des voies de désintoxication
- L’hydratation : Boire une quantité suffisante d’eau soutient la fonction rénale et favorise l’élimination des toxines, y compris les particules de graphène, par l’urine.
- Soutien du foie : La consommation d’aliments riches en antioxydants, tels que les baies et les légumes verts à feuilles, peut contribuer au fonctionnement du foie et améliorer le processus de désintoxication.
- Transpiration : La pratique d’activités qui font transpirer, comme l’exercice physique ou les séances de sauna, peut contribuer à l’élimination des toxines par la peau.
Interventions diététiques - Régime riche en fibres : Une alimentation riche en fibres favorise un transit intestinal régulier et facilite l’élimination des toxines, y compris le graphène, par le système digestif.
- Aliments détoxifiants : L’incorporation d’aliments aux propriétés détoxifiantes naturelles, comme l’ail, la coriandre et les légumes crucifères tels que le brocoli et les choux de Bruxelles, peut aider l’organisme à éliminer les substances nocives.
Thérapie par chélation
La thérapie par chélation implique l’administration d’agents chélateurs qui se lient aux métaux lourds et autres toxines, facilitant ainsi leur élimination de l’organisme.
Suppléments de soutien
Certains suppléments peuvent aider à soutenir les processus naturels de détoxification de l’organisme et favoriser l’élimination des particules de graphène. Il s’agit notamment de : - Le glutathion : connu comme le principal antioxydant de l’organisme, le glutathion joue un rôle crucial dans la désintoxication. Une supplémentation en glutathion ou en ses précurseurs, tels que la N-acétyl-cystéine (NAC), peut renforcer la capacité de l’organisme à éliminer les toxines.
- Vitamine C : En tant qu’antioxydant puissant, la vitamine C peut aider à neutraliser le stress oxydatif causé par l’exposition au graphène et soutenir les processus de désintoxication globaux.
Les effets toxiques du graphène sur l’organisme ne peuvent être ignorés. De la formation de caillots sanguins anormaux et de troubles vasculaires à la destruction des globules rouges, le graphène présente des risques importants pour la santé qui nécessitent une étude approfondie.
La transmission potentielle de nanorobots de graphène entre des personnes vaccinées et des personnes non vaccinées ajoute un autre niveau de préoccupation, suscitant des discussions éthiques critiques sur le consentement éclairé et les conséquences involontaires des programmes de vaccination.
Pour répondre à ces questions urgentes, il est essentiel de donner la priorité à la recherche et de développer des stratégies globales pour l’élimination du graphène de l’organisme. Bien que des méthodes spécifiques pour éliminer le graphène en toute sécurité soient encore en cours.
d’élaboration, l’amélioration des voies naturelles de désintoxication, l’adoption d’un régime alimentaire sain et la thérapie par chélation sont des voies potentielles qui méritent d’être explorées.
La consultation d’experts en toxicologie environnementale ou en désintoxication peut fournir des informations précieuses et des recommandations personnalisées.
La conquête du cerveau et de la biologie humaine via les technologies intrusives, à distance, et injectées…
Au sujet du dernier brevet, de 2022, WO2022200297A1, requis par Agnès Pottier avec Xphelum, portant sur des nano-particules de Graphène injectées aux points d’acupuncture – pour les interfaces neuronales
http://xochipelli.fr/2023/04/nouvelles-des-brigades-anti-graphene-avril-2023/#022204

GRAPHENE ET ACUPUNCTURE
“Particles as neural interfaces”. WO2022200297A1. requis en février 2020!!!
GRAPHENE injecté aux points d’acupuncture. Tout va bien? Que va dire @mmtchi?

Au sujet des brevets nano-particulaires d’Agnès Pottier pour la gestion du cerveau
Voic quelques brevet requis par Agnès Pottier pour la gestion du cerveau:
“Nanoparticules pour l’amélioration des performances cérébrales ou le traitement du stress”. 2017. BR112020012215A2
“Nanoparticules pour le traitement d’un trouble neuronal”. 2017. US11497717B2
“Système comprenant des particules et un dispositif amovible à des fins thérapeutiques”. Il concerne également des particules et des compositions comprenant de telles particules, destinées à être utilisées pour traiter un sujet, souffrant d’une maladie, par l’acupuncture. 2020. WO2021213767A1.
“Nanoparticules enrobées utilisées pour moduler la polarisation électrique des neurones”. 2017. US11229705B2.






Le projet Héraclès nous décrit l’élément crucial de sa réussite dans James Bond : la redondance, le ciblage et la reproductibilité de l’ADN !
Et si l’ADN était encore un élément totalement fictif ?
Fake Science : le cas de l’ADN traité dans un article évoqué par le Dr. Thomas COWAN
« Êtes-vous troublé par tout ce discours sur l’ARN « messager », les protéines, les gènes, les génomes, l’ADN et les maladies contagieuses ? Eh bien, vous n’êtes pas seul et vous êtes confus exprès.
L’ADN. Existe-t-il comme le disent les jolies photos ? La théorie d’un plan dans le noyau de chaque cellule. Alors que j’essayais de rassembler toutes ces informations en un semblant de cohésion, je me suis soudainement demandé où étaient les chromosomes dans tout cela ? Personne ne les mentionne ni ce qu’ILS sont. Donc je les ai regardés. Soi-disant, l’ADN est enveloppé dans les «chromosomes» du noyau de nos cellules qui n’ont jamais été vus que lorsque les cellules se divisent (uniquement vus dans les cellules embryonnaires en d’autres termes). Ils voient ces chromosomes doubler et se diviser en nouvelles cellules lorsqu’ils se divisent en deux. Ce processus s’appelle la mitose. L’ADN ne peut pas être vu et les très rares « photos » de ce qu’on nous dit est que l’ADN est très douteux. Deux que j’ai recherchés ont même été supprimés d’Internet mais je les ai trouvés sur la machine de retour. Pourquoi les ont-ils supprimés ? Probablement parce qu’ils ont l’air si faux ! Malheureusement pour eux, ils ne ressemblent en rien à leur ADN de dessin animé.
Nous savons que les virus sont un mensonge basé sur la théorie des germes (un autre mensonge), mais maintenant on nous fait croire que les protéines peuvent soudainement propager la maladie d’une personne à l’autre en «éliminant» une protéine fictive qu’ils disent pouvoir forcer nos propres cellules à produire à leur rythme. enchère. Mais le peuvent-ils ? Ils mélangent la chimie et les mathématiques et les appliquent aux fonctions biologiques. C’est le monde matérialiste dans lequel vivent ces scientifiques. »
Le docteur Thomas Cowan nous parle de l’électrification de la Terre.
Il nous explique que chaque pandémie ces 150 dernières années, correspond à un saut quantique dans l’électrification de la Terre. Les maladies sont un empoisonnement. Nous savons que les prédateurs au pouvoir ont la technologie nécessaire pour modifier et intensifier l’électrification de la Terre et ses fréquences qui impactent l’humain comme tout le reste du vivant !
L’ADN n’existe pas. Ils peuvent peut-être effectuer des tests basés sur la race et la prédiction des maladies en examinant nos bactéries, mais il n’existe pas de molécule telle que «l’ADN» et toute science génétique est un gros canular. La «criminalistique de l’ADN» est un autre canular. Quelque chose qui a été implicitement reconnu par le MSM. Le FBI admet des failles dans l’analyse capillaire depuis des décennies La «structure» totalement constituée de l’ADN ressemble étroitement au caducée satanique, vu ici sur la statue de Baphomet. La vérité à la vue de tous … S’ils sont prêts à dire des mensonges évidents, comme l’idée que les bébés ne ressentent aucune douleur, alors ils mentent définitivement sur des choses que nous ne pouvons pas facilement vérifier …
Source : https://www.reddit.com/r/conspiracy/comments/62gd23/dna_does_not_exist/
Plutôt que des tests ADN (PCR) ils cartographient de manière assez précise les chromosomes en étudiant les variations (SNP) à partir d’un test « ADN » autosomal.
https://www.researchgate.net/figure/SNP-array-analysis-of-X-chromosomes-in-representative-ONB-tumor-samples-a-An-ONB-from-a_fig2_329709396a
Comment utiliser le Comparateur de Chromosomes en généalogie ? – Base de Connaissance de MyHeritage

https://education.myheritage.fr/article/how-to-use-chromosome-browsers-for-genealogy/
Il faut pouvoir le prouver avec de vraies images vu que la première « photo » date de 2012
30/11/2012 PHOTOS. Les premières images de l’ADN prises par des scientifiques italiens
Mon extrait vidéo sur l’ADN…
Il faut aussi tenir compte de la fraude virale, qui valide le culte de la vaccinologie à tout prix… et donc le contrôle eugéniste des populations par l’empoisonnement et l’injection forcée au nom d’une immunité toxique contre des contaminations par les germes totalement factices !

La FRAUDE VIRALE
Toute la virologie moderne relève de la « foi » – de la religion – et non de la science. Comme le démontre cette vidéo :
https://odysee.com/@cv19:b/Le-culte-de-la-virologie-%E2%80%93-150-ans-de-fraudes-m%C3%A9dicales-de-Pasteur-au-Covid-19:8
Dr. Stefan Lanka, Dr. Andrew Kaufman, Dr. Robert O. Young, le Dr. Thomas Cowan, Jeff Green et Dr. Alain Scohy
Je vous en offre un petit résumé très succinct – car la vidéo est longue…

Conclusion :
Tous les tarés du grand reset et de l’eugénisme qui rêvent de hacker le cerveau et qui ne jurent que par l’IA (Schwab, Harari, Alexandre…), visent en fait à se débarrasser du corps, qui dans leur esprit ne sert à rien… et d’accéder à l’étincelle divine du créateur original, afin d’y accéder ou d’en contrôler l’utilisation.

Voici une illustration du monde pervers dans lequel ces grands malades nous plongent de gré ou de force… Une image vaut mille mots !

Le film culte Invasion Los Angeles (« They live » en VO) transposé à aujourd’hui ne nous conduit qu’à une seule solution : FLB = Faut Les Buter !
Bien sûr, la solution intermédiaire pour ne pas vivre dans un film de James Bond où les méchants gagnent à tous les coups… est de simplement dire non haut et fort, de rejeter ces menaces et cette guerre perpétuelle tous azimuts contre la vie et le vivant, en gueulant plus fort que jamais notre volonté de regagner notre souveraineté… au moment même où nos libertés individuelles sont bafouées de tous les côtés au nom d’une propagande inversée et perverse.
L’avenir de plus en plus proche nous dira si nos derniers espaces de liberté deviendront purement intérieurs ou pourront s’exprimer sur notre environnement physique extérieur aussi…
Courage à nous, nous pouvons tous devenir nos propres 007 pour sauver nos âmes et trouver la sortie de ce chaos organisé vers notre esprit originel, car nous refusons ici-bas et maintenant autant qu’au-delà dans ce jeu de l’incarnation de servir de Numéro 6 de la série Le Prisonnier !